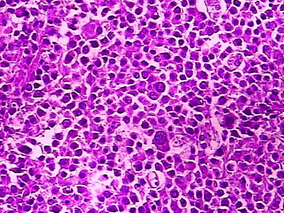
II-IV期滤泡型淋巴瘤：观察等待作初期管理可行吗？
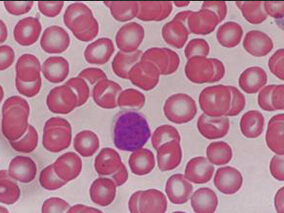
CLL患者ibrutinib治疗期间自身免疫性血细胞减少症的发生率

-
老年霍奇金淋巴瘤患者:降低强度VEPEMB方案vs标准ABVD
环球医学资讯
 2016年03月31日
2016年03月31日 点击量:380
点击量:380 1小时条评论
1小时条评论在儿童和年轻成人霍奇金淋巴瘤(HL)患者中获得满意疗效的现代化疗和放疗,对老年患者疗效如何?2016年3月发表在《British Journal of Haematology》的一项在意大利开展的研究表明,老年霍奇金淋巴瘤患者接受标准ABVD方案治疗的PFS和OS优于VEPEMB。 近年,老年霍奇...
-
II-IV期滤泡型淋巴瘤:观察等待作初期管理可行吗?
环球医学资讯
 2016年03月31日
2016年03月31日 点击量:431
点击量:431 1小时条评论
1小时条评论滤泡型淋巴瘤(FL)在治疗上以保守治疗为主,化疗反应好,但不能治愈,病程长。2016年1月发表在《British Journal of Haematology》的一项在美国开展的研究表明,观察等待作为初期管理在序贯治疗的背景下,对于现代FL患者依然是一个可行的选择。 为检查临床实践中滤...
-
CLL患者ibrutinib治疗期间自身免疫性血细胞减少症的…
环球医学资讯
 2016年03月30日
2016年03月30日 点击量:229
点击量:229 1小时条评论
1小时条评论慢性淋巴细胞白血病(CLL)是西方国家最常见的成人白血病,它主要影响平均年龄72岁的老年患者。CLL常并发继发性自身免疫性血细胞减少(AICS),Ibrutinib治疗对ACI发病的影响目前尚是未知。2016年2月,发表在《Leukemia》上的一项研究显示,ibrutinib治疗期间ACI的估...
-
哪些因素促使成人急淋患者的生存期得到改善?
环球医学资讯
 2016年03月30日
2016年03月30日 点击量:430
点击量:430 1小时条评论
1小时条评论2016年2月,发表在《Leukemia》上的一项全国性基于人群的研究对荷兰急性淋巴细胞白血病患者的治疗、研究参与和生存期的趋势进行了评估。结果显示,70岁以下的患者随着时间推移生存期均得到改善。 该项研究收集1989年至2012年期间,向荷兰癌症注册处报告的1883例确诊...
-
老年AML患者阿扎胞苷联合强化诱导化疗是否有获益?
环球医学资讯
 2016年03月30日
2016年03月30日 点击量:513
点击量:513 1小时条评论
1小时条评论急性髓细胞白血病(AML)是一种常见的造血系统恶性克隆性疾病,随着造血干细胞移植等技术的进步,其预后已明显改善,但对于年龄大于60岁的AML患者,标准化疗疗效欠佳。2016年3月,发表在《Leukemia》上的一项研究显示,阿扎胞苷添加到标准化疗中增加老年AML患者的毒...
-
骨髓增生异常综合征患者G-CSF和GM-CSF+标准治疗的证据
环球医学资讯
 2016年03月29日
2016年03月29日 点击量:272
点击量:272 1小时条评论
1小时条评论骨髓增生异常综合征(MDS)的特点是髓系细胞分化及发育异常,表现为无效造血、难治性血细胞减少、造血功能衰竭。2016年2月,发表在《Cochrane Database Syst Rev》的一项由德国科学家进行的系统评价考察了MDS患者G-CSF和GM-CSF+标准治疗的证据。 背景:骨髓增生异常...
-
新发CML患者长期治疗结局:干细胞移植vs化疗
环球医学资讯
 2016年03月29日
2016年03月29日 点击量:150
点击量:150 1小时条评论
1小时条评论慢性髓性白血病(CML)是一种因正常髓样细胞恶变引起的骨髓增殖性疾病。酪氨酸激酶抑制剂是当今治疗CML的首选。异基因造血干细胞移植(HSCT)被认为是挽救治疗。2016年3月,发表在《Leukemia》的一项研究对两种治疗方法治疗新发CML患者的长期治疗结局进行比较。 酪...
-
老年新发MM:序贯还是交替VMP+Rd?
环球医学资讯
 2016年03月29日
2016年03月29日 点击量:429
点击量:429 1小时条评论
1小时条评论硼替佐米联合美法仑和强的松(VMP)及来那度胺联合低剂量地塞米松(Rd)是未经治疗的多发性骨髓瘤(MM)老年患者的两种标准治疗方法。2016年1月,发表在《Blood》的一项研究试图比较连续或交替使用VMP和Rd18个疗程的疗效差异。结果显示,目前基于VMP和Rd的治疗方案,...
-
老年新发MM:三联vs双联含来那度胺方案
环球医学资讯
 2016年03月28日
2016年03月28日 点击量:279
点击量:279 1小时条评论
1小时条评论来那度胺-地塞米松能改善老年新发多发性骨髓瘤患者预后。2016年3月,发表在《Blood》的一项研究对三联vs双联含来那度胺方案治疗老年新发多发性骨髓瘤的疗效进行分析。结果表明,含烷化剂的三联MPR(美法仑-强的松-来那度胺)和CPR(环磷酰胺--强的松-来那度胺)并不...
-
TKI治疗CML的最佳时机选择
环球医学资讯
 2016年03月28日
2016年03月28日 点击量:312
点击量:312 1小时条评论
1小时条评论过去20年,酪氨酸激酶抑制剂(TKI)飞速发展,极大地改善了慢性粒细胞白血病(CML)的治疗效果。在CML患者中,延迟TKI治疗对生存、细胞遗传学缓解和分子生物学缓解有何影响呢?2016年2月,发表在《Br J Haematol.》的一项研究对此进行分析。 发展中和低收入国家的肿...

会员登录
会员登录

